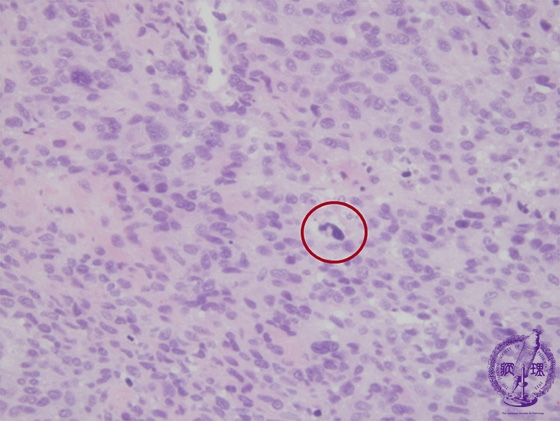

- 18.Soft tissue
- ★(2)Malignant peripheral nerve sheath tumor(MPNST)
Microscopic findings (H.E. high power view): Spindle-shaped tumor cells markedly atypical with many mitotic figures and nuclear polymorphism, such as giant nuclei (red circle).
Click the image to see the enlarged image.